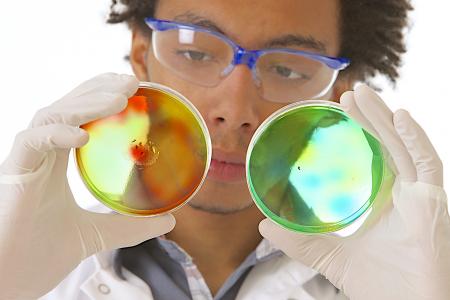
Certaines bactéries hospitalières résistantes aux médicaments persistent même après un nettoyage en profondeur de l’hôpital (Visuel Adobe Stock 53717225)

INFECTIONS NOSOCOMIALES : Ces bactéries qui résistent aussi à l’hygiène hospitalière
Certaines bactéries hospitalières résistantes aux médicaments persistent même après un nettoyage en profondeur de l’hôpital révèle cette étude de l’Université de Cambridge. Ces hygiénistes qui publient dans la revue Nature Microbiology utilisent le séquençage du génome pour révéler la mesure dans laquelle une bactérie gastro-intestinale peut se propager dans un hôpital, démontrant l’ampleur du défi auquel sont confrontés les hôpitaux avec ces infections bactériennes émergentes.
Enterococcus faecium est une bactérie que l'on trouve couramment dans le tractus gastro-intestinal, où elle réside généralement sans causer de problèmes à l'hôte. Cependant, chez les patients immunodéprimés, la bactérie peut entraîner une infection mortelle. Ces 30 dernières années, des souches d’E faecium sont ainsi devenues résistantes aux antibiotiques de première ligne, dont l'ampicilline et la vancomycine, limitant les options de traitement et déclenchant des infections nosocomiales.
La propagation de ces infections résistantes nous oblige à comprendre où vit la bactérie,
quels sont ses « réservoirs » et par quelles voies elle se transmet.
Les scientifiques de Cambridge avec leurs collègues de la London School of Hygiene and Tropical Medicine ont développé une approche qui combine des données épidémiologiques et génomiques et permet de cartographier la propagation des bactéries dans les établissements de soins de santé. Cela permet aux hôpitaux d’identifier les sources des infections et de cibler les mesures de contrôle. Ici, l'équipe applique cette approche à la propagation d'E. Faecium résistante aux médicaments, en milieu hospitalier.
Le séquençage du génome entier de la bactérie combiné à un échantillonnage détaillé des patients et de l'environnement offre un outil puissant permettant de cartographier la voie de propagation de l’infection et de prévenir de nouvelles flambées. L'équipe a suivi durant 6 mois, 149 patients en hématologie admis dans des établissements du NHS Foundation Trust, prélevé des échantillons de selles des patients et des écouvillons dans l'environnement hospitalier et les ont cultivés pour E. faecium.
L'analyse génomique de la bactérie a permis d’identifier le « chemin » de la bactérie.
Sur 101 patients pouvant être suivis, l'analyse génomique révèle ici que :
- les deux tiers des patients ont contracté E. faecium (vs moins de la moitié en utilisant uniquement des méthodes de culture) ;
- un peu moins de la moitié (48%) des écouvillons prélevés en milieu hospitalier étaient positifs pour E. faecium résistant à la vancomycine : soit 36% des dispositifs médicaux, 76% des zones non tactiles telles que les bouches d'aération, 41% des lits et 68% des salles de bain communes testées.
Même un nettoyage en profondeur ne parvient pas à éradiquer les bactéries. L'hôpital a en effet entrepris un programme de nettoyage et de désinfection en profondeur dans un service sur une période de 3 jours au cours de l'étude, cependant, lorsque l'équipe échantillonne différents sites de l’hôpital
- avant le retour des patients dans le service, elle constate que 9% des échantillons sont toujours positifs à la bactérie ;
- dans les 3 jours suivant le retour des patients dans le service, environ la moitié des sites échantillonnés sont testés positifs ;
- 74% des patients sont porteurs d’une souche multirésistante d'E. Faecium couramment observée dans les hôpitaux, résistante à l'antibiotique ampicilline et qui acquiert une résistance à la vancomycine ;
- parmi ces patients, plus de la moitié présentent de forts liens épidémiologiques et génomiques avec au moins un autre patient et / ou leur environnement direct.
Ces résultats indiquent que ces patients ont été infectés par la bactérie multirésistante pendant leur séjour à l'hôpital.
Une analyse génomique plus poussée révèle également plusieurs sous-types de la bactérie résistante. Il n’est pas rare qu'un patient soit porteur de plus d'un sous-type, une donnée qui serait restée inconnue sans l’analyse génomique détaillée. Au total, 115 sous-types ont été recensés mais 28% des infections sont le fait de 2 sous-types seulement.
On retiendra que certaines bactéries résistantes aux médicaments peuvent persister dans l'environnement hospitalier malgré un nettoyage en profondeur et à des niveaux élevés, en dépit l'utilisation de produits de nettoyage et de désinfection à l'efficacité démontrée, et de protocoles pourtant validés.
L’étude montre à quel point il peut être difficile de lutter contre les infections nosocomiales. Le dépistage des patients, la mise à disposition d'installations d'isolement et de toilettes privatives, l’amélioration des protocoles de nettoyage et des pratiques d'hygiène sont donc plus que jamais nécessaires pour enrayer cette émergence mondiale de superbactéries.
Sans oublier de lutter contre l'usage inapproprié des antibiotiques.
Autres actualités sur le même thème
ARTHROPLASTIE de la HANCHE : La chirurgie robotique fait ses preuves
Actualité publiée il y a 2 années 2 moisINFECTIONS NOSOCOMIALES : Des vêtements respirants, antibactériens et intelligents
Actualité publiée il y a 6 années 7 moisTRAUMATOLOGIE : Une check-list pour des soins complexes
Actualité publiée il y a 6 années 9 moisHÔPITAL : Délivrer les médicaments en fonction du patient, pas du planning
Actualité publiée il y a 6 années 6 mois




